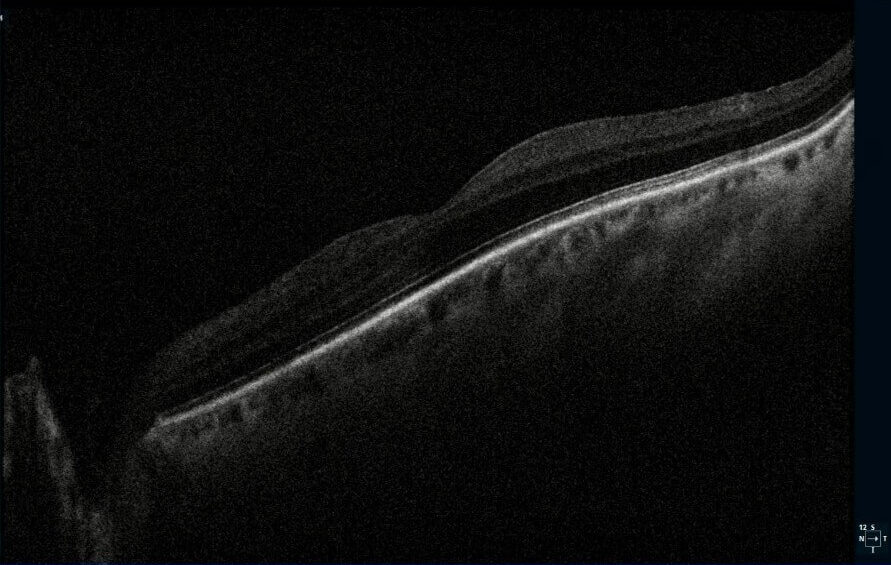
photo essay figure 2 (medium)

Photo Essay – A Spiral Illusion: An Atypical Presentation of Schlaegel Lines

Abstract
This brief report reviews the epidemiology, etiologies, and clinical presentation of Schlaegel Lines. It also reviews a case report showing an atypical presentation of Schlaegel lines secondary to inactive multifocal choroiditis which gives the appearance of spiral retinopathy. The presence of Schlaegel lines and underlying choroiditis can lead to complications such as choroidal neovascularization, requiring close monitoring and prompt anti-VEGF treatment.
Keywords: choroiditis, chorioretinal, neovascularization, retinal pigment epithelium, Schlaegel lines
INTRODUCTION
Schlaegel lines are distinctive, pigmented or depigmented curvilinear streaks within the retinal pigment epithelium (RPE) and choroid that often radiate or curve from the posterior pole toward the midperiphery.1-3 These lines are thought to represent areas of RPE disruption and chorioretinal scarring secondary to inflammatory or infectious processes.1-3 They can be associated with idiopathic multifocal choroiditis and panuveitis (MCP), presumed ocular histoplasmosis syndrome (POHS), tuberculous choroiditis, ocular syphilis, and ocular toxoplasmosis.1-3 Although the exact prevalence is unknown, Schlaegel lines remain a relatively rare finding and are often discovered incidentally during dilated fundus examination or widefield retinal imaging.1-4 Here we review the clinical features of Schlaegel lines, their epidemiology and etiologies, and present a case of Schlaegel lines in a spiral pattern secondary to inactive multifocal choroiditis.
CASE REPORT
A 67-year-old male presented for a routine eye exam. The patient reported no visual complaints and denied ocular pain, photopsia, new floaters, metamorphopsia, or diplopia. His medical history included obesity and no history of systemic inflammatory or infectious disease. He denied any history of ocular trauma or surgery. The patient’s uncorrected and corrected visual acuity was 20/20 in each eye. Extraocular muscles, confrontation fields and pupils were normal. Slit-lamp examination for the right and left eye was unremarkable. Following dilation with 1% tropicamide and 2.5% phenylephrine, funduscopic examination was performed. The optic discs were normal with a cup-to-disc ratio 0.30 round. The macula in each eye was flat with normal OCT (Figure 1-2). However, examination of both eyes revealed multiple, curvilinear, pigmented chorioretinal lines originating in the posterior pole and extending outward in a distinct spiral pattern toward the midperiphery. Color fundus photographs as well as fundus autofluorescence images were obtained (Figures 3-6). There was also a punched-out chorioretinal lesion nasal to the optic nerve head in the right eye (Figure 3,5).
The patient’s history and examination were most consistent for inactive multifocal choroiditis with Schlaegel lines. The unusual spiral pattern was considered an atypical presentation based on previous evaluation by a retina specialist.

Figure 3: Widefield color fundus photography of the right eye showed a single punched-out chorioretinal lesion with peripheral curvilinear pigmented chorioretinal streaks.

Figure 4: Widefield color fundus photography of the left eye showed peripheral curvilinear pigmented chorioretinal streaks.

Figure 5: Fundus autofluorescence of the right eye showed mixed areas of hypo- and hyperautofluorescent lines corresponding to RPE atrophy and hyperplasia, with a hypoautofluorescent area nasal to the optic nerve head consistent with an inactive punched-out lesion.

Figure 6: Fundus autofluorescence of the left eye showed mixed areas of hypo- and hyperautofluorescent lines corresponding to RPE atrophy and hyperplasia.
DISCUSSION
Schlaegel lines are markers of inactive chorioretinal inflammation, appearing as curvilinear chorioretinal streaks that are often pigmented and follow arcuate or radial patterns.1-3 They are thought to result from damage to the RPE and choroid during episodes of active inflammation or infection.4 As the lesions heal, pigment from damaged RPE cells migrates and clumps along the lesion edges and creates the curvilinear appearance. Over time, these lines may become more pigmented or atrophic depending on the chronicity and severity of the initial immunologic reaction. The prevalence remains uncertain, as most patients are asymptomatic and lesions are often found incidentally. Vision is affected if the lesions encroach into the macula or lead to secondary complications such as CNV.4 When symptomatic, patients may describe decreased central vision, metamorphopsia, paracentral scotomas, or photopsias.
Etiologies
Non-infectious causes of linear chorioretinal lesions include multifocal choroiditis and uveitis (MCP), presumed ocular histoplasmosis syndrome (POHS), punctate inner choroidopathy (PIC), and birdshot chorioretinopathy. Infectious causes include tuberculosis, syphilis, toxoplasmosis, and viral choroiditis. Trauma and degenerative changes of the retinal pigment epithelium are uncommon etiologies. MCP is a chronic, relapsing inflammatory disorder that causes punched-out lesions in the posterior pole and mid-periphery, which may later become chorioretinal scars. POHS is characterized by punched-out chorioretinal scars, peripapillary atrophy, and choroidal neovascularization (CNV), with some patients also developing linear peripheral streaks. PIC presents with small, yellow-white lesions in the posterior pole without vitreous inflammation and, like MCP and POHS, can progress to atrophic scars or CNV.
Differential Diagnosis
- Angioid streaks present as radiating lines from the optic disc due to breaks in Bruch’s membrane that are often associated with systemic diseases such as pseudoxanthoma elasticum. Unlike Schlaegel lines, they are deeper, reddish-brown, and more radially oriented.11-12
- Lacquer cracks are linear breaks in Bruch’s membrane seen in pathologic myopia and typically yellow-white and located in the macular region.13
- Choroidal ruptures from blunt trauma are crescent-shaped with forked or tapered endings that appear as white-yellow lesions in the posterior pole.14
- Botfly larvae, belonging to the order Diptera, may invade the eye and lead to damage of the RPE as it progresses through the subretinal space. Unlike Schlaegel lines, these subretinal tracks are formed by the invasion of the living larvae and are unilateral, numerous and often cross one another in a criss-cross patterns.15
- In addition to the classic triad of POHS, which includes chorioretinal scars (“histo spots”), peripapillary atrophy, and choroidal neovascularization, some patients also develop peripheral streak lesions. These curvilinear lesions are usually found near the equator and run parallel to the ora serrata.7-9
Management and Prognosis
In inactive cases, no immediate treatment is necessary. Regular monitoring is important to detect complications such as CNV. Active inflammation may require oral corticosteroids or non-steroidal immunosuppressive agents, depending on the etiology.4,8 Infectious etiologies require targeted antimicrobial therapy.
The long-term prognosis depends largely on lesion location and the presence or absence of CNV. In cases where the fovea remains unaffected, visual acuity is often preserved for many years.
CONCLUSION
This case describes an unusual spiral pattern of Schlaegel lines in a patient with inactive multifocal choroiditis. Although most often associated with inflammatory chorioretinal disease, it is important to differentiate Schlaegel lines from other differentials, including angioid streaks, lacquer cracks, and parasitic subretinal tracks. Regular follow-up with fundus photography and OCT is necessary, as these diagnostic tools allow for early detection of recurrent inflammation or choroidal neovascularization, a potentially vision-threatening complication.
REFERENCES
- Ferreira de Moura T, Henry A, Arndt C, Denoyer A, Collot L. Schlaegel lines in a pediatric case of idiopathic multifocal choroiditis. J Fr Ophtalmol. 2022 Nov;45(9):e415-e416. doi: 10.1016/j.jfo.2022.05.004. Epub 2022 Jul 4. PMID: 35798619.
- Feo A, Sarraf D. Schlaegel Lines 360 Degrees in Punctate Inner Choroidopathy. Ophthalmol Retina. 2025 Jan;9(1):e2. doi: 10.1016/j.oret.2024.05.015. Epub 2024 Jul 1. PMID: 38958617.
- Schechet SA, Kotlyar B, Raiji VR. Multimodal Imaging of Double Schlaegel Lines. Ophthalmol Retina. 2019 May;3(5):443. doi: 10.1016/j.oret.2019.01.008. PMID: 31044737.
- Somkijrungroj T, Pearlman JA, Gonzales JA. Multifocal choroiditis and panuveitis presenting with progressive equatorial linear streaks: evolution of Schlaegel lines documented with multimodal imaging. Retin Cases Brief Rep. 2015 Summer;9(3):214-7. doi: 10.1097/ICB.0000000000000141. PMID: 25790317.
- Hady SK, Xie S, Freund KB, Cunningham ET Jr, Wong CW, Cheung CMG, Kamoi K, Igarashi-Yokoi T, Ali OM, Wasfi EI, Rateb MF, Ohno-Matsui K. Prevalence and characteristics of multifocal choroiditis/punctate inner choroidopathy in pathologic myopia eyes with patchy atrophy. Retina. 2022 Apr 1;42(4):669-678. doi: 10.1097/IAE.0000000000003383. PMID: 34934033.
- Chen C, Cheng Y, Zhang Z, Zhang Y, Xiao Y, Peng X. Clinical characteristics of streaky multifocal choroiditis: a subtype of multifocal choroiditis. Retina. 2022 Nov 1;42(11):2110-2119. Doi: 10.1097/IAE.0000000000003569. PMID: 35839489.
- Fountain JA, Schlaegel TF Jr. Linear streaks of the equator in the presumed ocular histoplasmosis syndrome. Arch Ophthalmol. 1981 Feb;99(2):246-8. doi: 10.1001/archopht.1981.03930010248004. PMID: 7469859.
- Ciulla, Thomas A. MD*; Piper, Heidi C. MD*; Xiao, Matthew MD, PhD*; Wheat, L. Joseph MD†. Presumed ocular histoplasmosis syndrome: update on epidemiology, pathogenesis, and photodynamic, antiangiogenic, and surgical therapies. Current Opinion in Ophthalmology 12(6):p 442-449, December 2001.
- Diaz RI, Sigler EJ, Rafieetary MR, Calzada JI. Ocular histoplasmosis syndrome. Surv Ophthalmol. 2015 Jul-Aug;60(4):279-95. doi: 10.1016/j.survophthal.2015.02.005. Epub 2015 Mar 5. PMID: 25841248.
- Kalogeropoulos D, Rahman N, Afshar F, Hall N, Lotery AJ. Punctate inner choroidopathy: A review of the current diagnostic and therapeutic approaches. Prog Retin Eye Res. 2024 Jan 3;99:101235. doi: 10.1016/j.preteyeres.2023.101235.
- Tsokolas G, Tossounis C, Tyradellis S, Motta L, Panos GD, Empeslidis T. Angioid Streaks Remain a Challenge in Diagnosis, Management, and Treatment. Vision (Basel). 2024 Mar 5;8(1):10. doi: 10.3390/vision8010010. PMID: 38535759; PMCID: PMC10976272.
- Georgalas I, Papaconstantinou D, Koutsandrea C, Kalantzis G, Karagiannis D, Georgopoulos G, Ladas I. Angioid streaks, clinical course, complications, and current therapeutic management. Ther Clin Risk Manag. 2009 Feb;5(1):81-9. Epub 2009 Mar 26. PMID: 19436620; PMCID: PMC2697526.
- Neelam K, Ng SMS, Ho EL, Au Eong KG. Lacquer cracks in pathological myopia: a clinical review. Eye (Lond). 2024 Oct;38(15):2859-2873. doi: 10.1038/s41433-024-03183-1. Epub 2024 Aug 8. PMID: 39117703; PMCID: PMC11461616.
- Lupidi M, Muzi A, Castellucci G, Kalra G, Piccolino FC, Chhablani J, Cagini C. The choroidal rupture: current concepts and insights. Surv Ophthalmol. 2021 Sep-Oct;66(5):761-770. doi: 10.1016/j.survophthal.2021.01.014. Epub 2021 Feb 2. PMID: 33545177.
- Gass JD, Lewis RA. Subretinal tracks in ophthalmomyiasis. Arch Ophthalmol. 1976 Sep;94(9):1500-5. doi: 10.1001/archopht.1976.03910040334008. PMID: 962662.